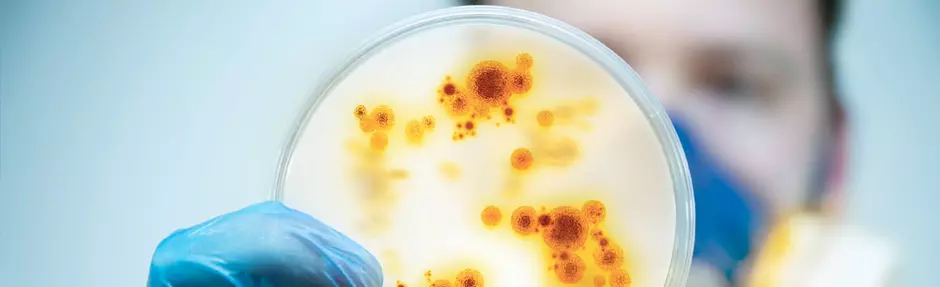
Água Ultrapura em Microbiologia

Bem-vindo ao Lab Experience, seu centro de excelência em água laboratorial.
Explore conteúdo especializado sobre água ultrapura, técnicas analíticas e protocolos laboratoriais. Descubra as melhores práticas em purificação e soluções personalizadas para otimizar a rotina do seu laboratório.
Aqui, a expertise técnica encontra a inovação para garantir resultados precisos em suas análises.
Guia da Água Ultrapura
Descubra como escolher a água ideal para seu laboratório, evite contaminações e economize tempo e recursos. Este guia completo aborda desde especificações técnicas até as melhores práticas de uso.
A Importância da água ultrapura para resultados precisos em análises laboratoriais
Descubra por que a água ultrapura é essencial para resultados analíticos confiáveis e como diferentes tecnologias de purificação garantem a máxima qualidade em suas análises.
Monitoramento e Controle de Qualidade da Água Ultrapura: Parâmetros Críticos e Sistemas de Gerenciamento
Descubra como o monitoramento preciso e contínuo da água ultrapura é essencial para seus resultados laboratoriais. Conheça os parâmetros críticos e as tecnologias que asseguram a máxima pureza em suas análises.
Análise de Ultratraços: Desafios e Soluções na Química Analítica Moderna
Explore os desafios e soluções na análise de ultra-traços, incluindo técnicas analíticas avançadas, requisitos de pureza da água e controle de contaminantes em química analítica.
Água Ultrapura em Análises Laboratoriais: Garantindo Confiabilidade e Reprodutibilidade em Resultados Analíticos
Maximize o potencial analítico do seu laboratório através de práticas otimizadas de purificação e monitoramento contínuo da qualidade da água.
Água Ultrapura em Microbiologia: Aplicações e Tecnologias Avançadas
Garanta a excelência dos seus resultados microbiológicos!
Não deixe que a qualidade da água comprometa suas pesquisas. Descubra como a água ultrapura PURELAB pode transformar a precisão e reprodutibilidade dos seus experimentos.
Como maximizar a vida útil dos sistemas de purificação com serviços pós-venda especializados
Descubra como os serviços pós-venda da Veolia ajudam a prolongar a vida útil e o desempenho dos sistemas de purificação de água.
Quer receber conteúdos, estudos exclusivos, convites para eventos e muito mais?
Clique aqui e se inscreva!
Continue navegando
Soluções de Purificação de Água
Descubra as soluções de purificação de água ELGA para laboratórios. Desde água ultrapura Tipo I até água Tipo III, temos o sistema ideal para suas necessidades de pesquisa.
Aplicações Laboratoriais
Descubra a solução perfeita para sua aplicação. Garanta a pureza ideal para cada protocolo específico, desde análises ultrassensíveis até procedimentos rotineiros.
Fale com um especialista
Entre em contato com um de nossos especialistas, invista em soluções inteligentes de purificação de água de laboratório.